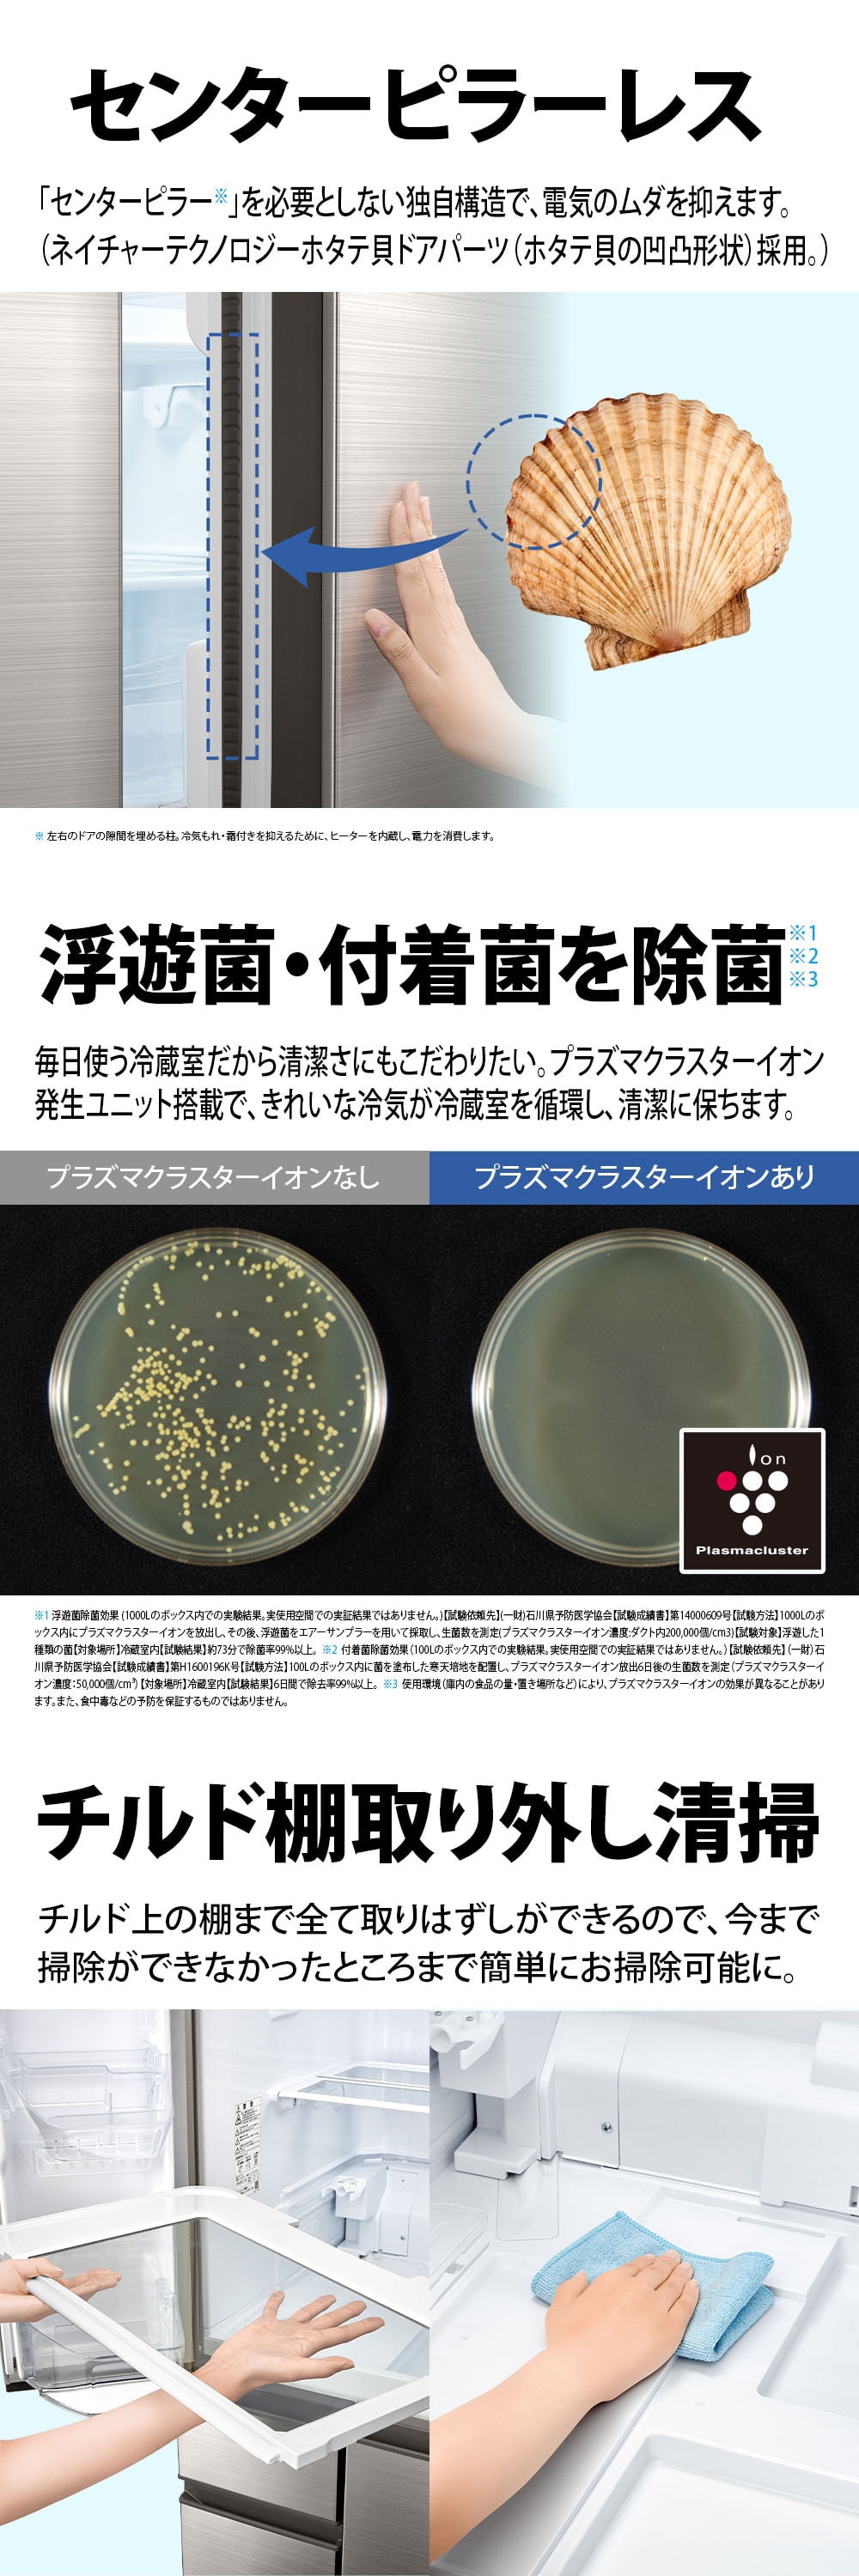
SJ-SF50P-S 詳細画像3

SHARP SJ-SF50P-S ステンレスシルバー [冷蔵庫 (502L・フレンチドア/観音開き)]
高品位ステンレスドア採用・大容量冷凍室メガフリーザー170L
商品コード:300000156922701 |
- 商品状態
- 新品
- 価格
-
¥ 154,998 (税込)
- 送料無料
- ポイント
-
0ポイント
- ポイント対象外商品です。
- 詳細はこちら
- 在庫状況
- 在庫あり
- 配送・設置
-
- 最短 2026年03月02日(月) に出荷
- 大型商品のご注文からお届け・設置工事までの流れ
- 大型配送・設置サービス 空き状況
- 沖縄・離島・一部市区町村へのお届けは追加料金をご負担いただきます

★ 野菜の甘みを引き出す「雪下シャキット野菜室」
★ クリーンな冷気が庫内を循環「プラズマクラスター」
| 基本仕様 | |
|---|---|
| タイプ | 冷凍冷蔵庫 |
| ドアの開き方 | フレンチドア(観音開き) |
| ドア数 | 6 ドア |
| 使用人数 | 5人以上 |
| 冷却方式 | 間冷式(ファン式) |
| ドア素材 | ステンレスドア |
| ポータブル | |
| 日本製 | |
| 容量(JIS C:2015) | |
| 定格内容積 | 502 L |
| 冷凍室 | 149L <97L> |
| 冷蔵室 | 259L <198L>うち、チルドルーム18L |
| 野菜室 | 73L <49L> |
| 切り替え室 | |
| 独立製氷室 | 21L <6L> |
| サイズ・質量 | |
| 幅x高さx奥行き | 幅685x高さ1833x奥行699(ハンドル・調節脚部カバー含む:704) mm |
| 質量 | 92 kg |
| 製氷・冷凍機能 | |
| 自動製氷 | ○ |
| 急速製氷 | ○ |
| 急速冷凍 | ○ |
| 解凍モード | |
| 省エネ性能(JIS C:2015) | |
| 多段階評価点 | 3.4 |
| 省エネ基準達成率 | 100%(2021年度) |
| 省エネ性マーク(緑) | ○ |
| 年間消費電力(50Hz) | 291 kWh |
| 年間消費電力(60Hz) | 291 kWh |
| 年間電気代(50Hz) | 7857 円 |
| 年間電気代(60Hz) | 7857 円 |
| カラー | |
| カラー | ステンレスシルバー |
| レイアウト | |
| 真ん中野菜室 | ○ |
| 真ん中冷凍室 | |
| 操作・アシスト機能 | |
| スマホ連携 | |
| タッチオープン | |
| タッチパネル(操作) | |
| 音声対話 | |
| 閉め忘れ防止 | ○ |
| カメラ搭載 | |
| その他機能 | |
| 脱臭 | ○ |
| 除菌 | ○ |
| 耐熱トップテーブル | |
| 節電モード | ○ |
| 冷蔵・チルド機能 | |
| チルド室 | ○ |
| パーシャル室 | |
| 野菜の鮮度保持 | 雪下シャキット野菜室 |
| 肉・魚の長期保存 | |
| ラップなし | |
-
No.1
日立 R-H49X(W) ピュアホワイト Hタイプ [冷蔵庫 (485L・フレンチドア/観音開き)]
¥ 158,422(税込)
在庫有り(本日千葉物流センターより出荷)
送料: 無料
一緒に買う -
No.2
PANASONIC NR-C33ES1-C マットベージュ [冷蔵庫 (326L・右開き)]
¥ 94,443(税込)
在庫有り(本日千葉物流センターより出荷)
送料: 無料
一緒に買う -
No.3
東芝 GR-Y640XFS(TH) フロストグレージュ VEGETA XFSシリーズ [冷蔵...
¥ 265,134(税込)
在庫残少 ご注文はお早めに
送料: 無料
一緒に買う -
No.4
Hisense HR-K12HB ブラック [冷蔵庫 (124L・右開き)]
¥ 23,800(税込)
在庫有り(本日千葉物流センターより出荷)
送料: 無料
一緒に買う

![日立 R-H49X(W) ピュアホワイト Hタイプ [冷蔵庫 (485L・フレンチドア/観音開き)] 日立 R-H49X(W) ピュアホワイト Hタイプ [冷蔵庫 (485L・フレンチドア/観音開き)]](http://pics.xprice.co.jp/i/5099/4549873215099M.jpg)
![PANASONIC NR-C33ES1-C マットベージュ [冷蔵庫 (326L・右開き)] PANASONIC NR-C33ES1-C マットベージュ [冷蔵庫 (326L・右開き)]](http://pics.xprice.co.jp/i/8288/4549980788288M.jpg)
![東芝 GR-Y640XFS(TH) フロストグレージュ VEGETA XFSシリーズ [冷蔵庫 (643L・フレンチドア/観音開き)] 東芝 GR-Y640XFS(TH) フロストグレージュ VEGETA XFSシリーズ [冷蔵庫 (643L・フレンチドア/観音開き)]](http://pics.xprice.co.jp/i/9209/4904530129209M.jpg)
![Hisense HR-K12HB ブラック [冷蔵庫 (124L・右開き)] Hisense HR-K12HB ブラック [冷蔵庫 (124L・右開き)]](http://pics.xprice.co.jp/i/8008/0-4580341988008M.jpg)